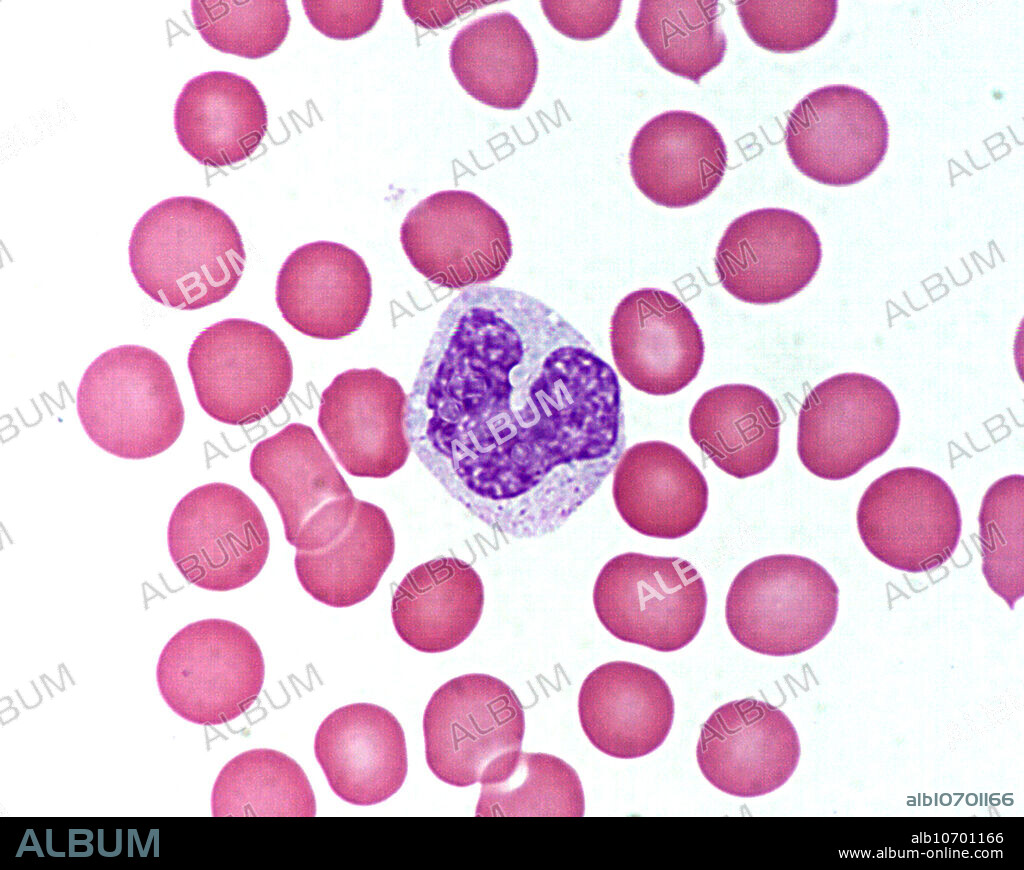

Моноцит процесс
Слова ты мой желанный
Как учить ребенка отвечать на вопросы
Field of silence
Историю конохи
12 ручек 24
A15 41m r309
Хеджирующая сделка
Какие номиналы банкнот доллара сша
Сон сено собирать
Где живет азиз
S27dg300ei
Демина магнитогорск
Upgrade to black крем для загара
Моноцит процесс 115 фотографий